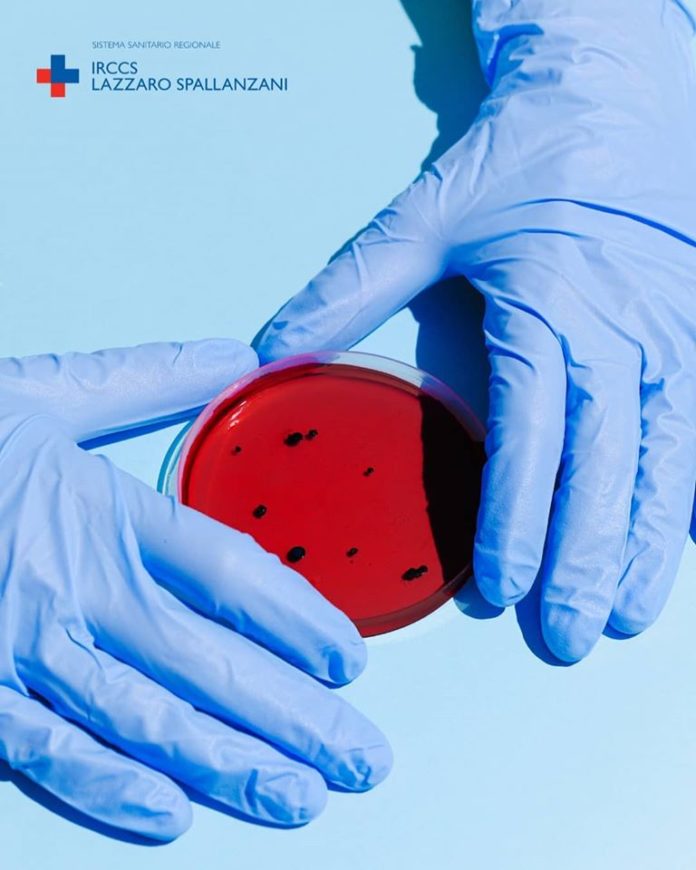
ricerca_spallanzani

“#CORONAVIRUS: D’AMATO, ‘LUNEDI’ 6 LUGLIO REGISTRIAMO 19 CASI E DI QUESTI 13 SONO CASI DI IMPORTAZIONE DI CUI 12 DEL BANGLADESH. UN NUOVO DECESSO. SI CONFERMA LA FORTE INCIDENZA DEI CASI DI IMPORTAZIONE, PRONTA ORDINANZA PER DISPORRE I TEST E I TAMPONI IN AEROPORTO SUI VOLI SPECIALI PROVENIENTI DA DACCA E IL CONTROLLO DELLE ASL DELLE CONDIZIONI DI ISOLAMENTO’
ASL ROMA 1: DEI SETTE CASI ODIERNI SONO SEI I CASI RIFERITI A PERSONE DI NAZIONALITA’ BANGLADESH CHE HANNO UN LINK CORRELABILE CON I VOLI INTERNAZIONALI PROVENIENTI DA DACCA GIA’ ATTENZIONATI;
ASL ROMA 2: SI REGISTRANO 6 CASI NELLE ULTIME 24H TUTTI DI NAZIONALITA’ BANGLADESH E DI QUESTI TRE HANNO UN LINK CORRELABILE CON I VOLI INTERNAZIONALI PROVENIENTI DA DACCA GIA’ ATTENZIONATI;
ASL ROMA 5: UN CASO DI UNA BAMBINA DI 11 ANNI RESIDENTE A MENTANA E TRASFERITA AL BAMBINO GESU’ DI PALIDORO, AVVIATA L’INDAGINE EPIDEMIOLOGICA;
ASL ROMA 6: UN NUOVO CASO SI TRATTA DI UN UOMO DI 37 ANNI DA ACCESSO AL PS DELL’OSPEDALE DEI CASTELLI TRASFERITO A SPALLANZANI;
NELLE PROVINCE SI REGISTRANO TRE CASI E DI QUESTI DUE NELLA ASL DI LATINA SI TRATTA DI UN UOMO CON INFARTO IN ACCESSO AL PRONTO SOCCORSO E UNA DONNA DI RIENTRO DALL’INDIA CHE ERA IN ISOLAMENTO, AVVIATA L’INDAGINE EPIDEMIOLOGICA, NELLA ASL DI VITERBO UN CASO DI UN UOMO IN FASE DI PRE-OSPEDALIZZAZIONE;
Lunedì 6 luglio registriamo un dato di 19 casi positivi e di questi 13 sono casi di importazione (12 del Bangladesh). Un nuovo decesso nelle ultime 24h. A Roma città sono 14 i nuovi casi. Si conferma la forte incidenza dei casi di importazione. Pronta l’ordinanza per disporre i test e i tamponi in aeroporto per i voli speciali provenienti da Dacca (Bangladesh) e il controllo demandato alle Asl delle condizioni di isolamento dei passeggeri. Oggi il volo in arrivo a Fiumicino alle ore 17.45. Dei nuovi casi giornalieri si registrano 12 casi di nazionalità Bangladesh e di questi 9 hanno un link correlabile con i voli internazionali provenienti da Dacca. Nella Asl Roma 1 dei sette casi odierni sono sei i casi riferiti a persone di nazionalità del Bangladesh che hanno un link correlabile con i voli già attenzionati provenienti da Dacca. Di questi sei nuovi casi quattro vivono in un unico domicilio. Nella Asl Roma 2 si registrano 6 casi tutti di nazionalità Bangladesh e di questi tre hanno un link correlabile con i voli già attenzionati provenienti da Dacca e i restanti tre casi sono giunti al pronto soccorso dell’ospedale Pertini. Nella Asl Roma 5 si registra una caso di una bambina di 11 anni residente a Mentana e trasferita all’ospedale pediatrico Bambino Gesù di Palidoro. Avviata l’indagine epidemiologica. Nella Asl Roma 6 un nuovo caso positivo di un uomo di 37 anni da accesso al pronto soccorso dell’ospedale dei Castelli e trasferito allo Spallanzani. Infine per quanto riguarda le province registriamo due casi nella Asl di Latina si tratta di un uomo colpito da infarto e individuato all’accesso del pronto soccorso e un secondo caso di una donna di nazionalità Indiana e di rientro dall’India che era in isolamento. E’ stata avviata l’indagine epidemiologia. Un terzo caso nella Asl di Viterbo e si tratta di un uomo individuato in fase di pre-ospedalizzazione”. Lo rendono noto Salute Lazio e Regione Lazio lunedì 6 luglio.